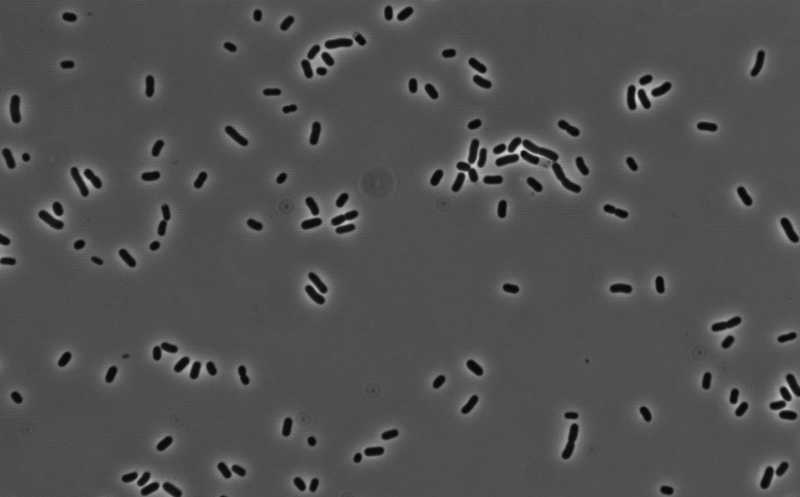

«Безобидные» бактерии ротовой и носовой полостей могут быть причиной внутрибольничных инфекций
Бактерии рода Klebsiella в норме обитают в носовой и ротовой полостях многих людей. Международная группа ученых показала, что при попадании в условия голодания, например, в больничной среде, они вытесняют других обитателей бактериального сообщества и могут вызывать внутрибольничные инфекции. Клебсиеллы обладают генами устойчивости ко многим антибиотикам, что повышает их потенциальную опасность для человека.
Credit:
Courtesy of Batbileg Bor, PhD, ADA Forsyth Institute | Пресс-релиз
Рот человека населен множеством микроорганизмов, которые никак не проявляют себя в здоровом организме, но при определенных условиях могут активно размножаться, вытесняя полезных членов микробиома. Некоторые бактерии при активном размножении повышают риск развития целого ряда неинфекционных хронических системных заболеваний, таких как диабет, рак и болезнь Альцгеймера. Другие бактерии, в норме входящие в состав микробиома полости рта (Streptococcus pyogenes, Streptococcus pneumoniae и Haemophilus influenzae), могут вызывать тяжелые инфекции — пневмонию, ангину, сепсис, менингит. И все эти бактерии могут распространяться от человека к человеку.
К этой группе относятся и бактерии из рода Klebsiella, обитающие в полости носа и в десневых карманах в полости рта; многие из них обладают генами устойчивости к антибиотикам. Например, Klebsiella pneumoniae входит в группу патогенов ESKAPE — особо опасных бактерий, вызывающих внутрибольничные инфекции, устойчивых сразу к нескольких видам антибиотиков и способных достаточно долго сохраняться на абиотических поверхностях (раковины, сливы). Схожими характеристиками обладают и другие виды клебсиелл: K. variicola, K. aerogenes и K. oxytoca. До настоящего момента считалось, что источником патогенных клебсиелл являются окружающая среда (почва, растения, животные), кишечник и кожа человека и больничная среда (поверхность раковин и стоков). Ротовая полость как потенциальный резервуар инфекции обычно врачами не рассматривается.
Международная команда ученых проанализировала, как бактерии рода Klebsiella ведут себя в условиях голодания in vitro. Такие условия на практике возникают, например, в ротовой полости при использовании аппаратов искусственной вентиляции легких (ИВЛ) и внутривенном питании.
В исследовании участвовали 30 здоровых добровольцев, которые сдавали пробы слюны (S1–S30) и мазки из носа (N1–N30). Микроорганизмы, обитающие в пробах, выращивали на питательных средах, а через некоторое время помещали в условия голодания на 30 и 120 дней. Чтобы оценить, как экстремальные условия влияют на состав микробиома, проводилось секвенирование областей V3-V4 генов 16s рРНК.
Клебсиеллы были обнаружены в шести назальных мазках из 30 (20%) и только в одном образце слюны из 30 (3,3%). В условиях голодания в назальных и оральных образцах снижался показатель альфа-разнообразия. Но если в образце изначально обнаруживались клебсиеллы, численность этих бактерий очень сильно возрастала. На твердых средах в условиях голодания к концу периода наблюдения большинство колоний были образованы видами из рода Klebsiella. Доминирующими являлись K. pneumoniae и K. aerogenes. То есть клебсиеллы остаются жизнеспособными даже в условиях голодания и при этом доминируют в микробиоме.
Интересно, что в отсутствие клебсиелл в оральных пробах начинала активнее размножаться бактерии Peptostreptoccocus, которые также могут быть причиной внутрибольничных инфекций и заболеваний пародонта.
Исследователи добавили клебсиелл к образцам, где изначально их не было. Оказалось, что в условиях голодания K. pneumoniae успешно размножаются в оральных и назальных образцах, вытесняя прежних членов микробиома. Но если в среде было достаточно питательных веществ, доля клебсиелл не увеличивалась. Причем микробные сообщества слюны лучше сопротивлялись разрастанию клебсиелл, чем назальные сообщества. Вероятно, в слюне имеются бактерии, способные контролировать размножение клебсиелл.
Штаммы K. pneumoniae, выделенные из носовой полости здоровых людей, оказались устойчивы к ампициллину, ванкомицину и коктейлю антибиотиков, включающему ванкомицин, триметоприм, цефсулодин и амфотерицин B. Два штамма также продемонстрировали частичную устойчивость к налидиксовой кислоте, а один штамм — устойчивость к эритромицину. Образцы, не содержащие клебсиелл, были восприимчивы к антибиотикам.
У клебсиелл достаточно большой и динамичный геном с богатым мобиломом (мобильными элементами, в том числе с плазмидами, интегративными конъюгативными элементами и др.). Это повышает их адаптивный потенциал и способность выживать в стрессовых условиях. Однако сравнительный анализ клебсиелл с другими бактериями с большим геномом показал, что успех клебсиелл обеспечивает наличие определенных генов и метаболических путей, которых нет у бактерий, не способных выжить в условиях голодания. Было также показано, что K. pneumoniae способна использовать питательные вещества погибших микробов.
Таким образом, ротовая и носовая полости могут выступать в качестве резервуара для колонизации условно-патогенными микроорганизмами, такими как бактерии из рода Klebsiella. В условиях голодания эти бактерии могут вытеснять других членов микробного сообщества и представлять собой угрозу для пациентов.
Патогенную микробиоту рта можно исследовать с помощью CRISPR
Источник:
Liu J., et al. Persistent enrichment of multidrug-resistant Klebsiella in oral and nasal communities during long-term starvation // Microbiome. 12, 132 (2024). DOI: 10.1186/s40168-024-01854-5


 Меню
Меню





 Все темы
Все темы




 0
0











